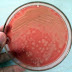

Pemeriksaan Mikrobiologi pada Sputum
Pemeriksaan sputum biasanya diperlukan jika diduga adanya penyakit paru. Membran mukosa saluran pernapasan berespons terhadap inflamasi dengan meningkatkan keluaran sekresi yang sering mengandung organisme penyebab. Perhatikan dan catat volume, konsistensi, warna dan bau sputum. Pemeriksaan sputum mencakup pemeriksaan :
Pewarnaan GRAM :
Pemeriksaaan dengan pewarnaan gram dapat memberikan informasi tentang jenis mikroorganisme untuk menegakkan diagnosis presumatif.Pewarnaan Gram atau metode Gram adalah suatu metode untuk membedakan spesies bakteri menjadi dua kelompok besar, yakni gram-positif dan gram-negatif, berdasarkan sifat kimia dan fisik dinding sel mereka.
Metode ini diberi nama berdasarkan penemunya, ilmuwan Denmark Hans Christian Gram (1853–1938) yang mengembangkan teknik ini pada tahun 1884 untuk membedakan antara pneumokokus dan bakteri Klebsiella pneumoniae.
Dengan metode pewarnaan Gram, bakteri dapat dikelompokkan menjadi dua, yaitu bakteri Gram positif dan Gram negatif berdasarkan reaksi atau sifat bakteri terhadap cat tersebut. Reaksi atau sifat bakteri tersebut ditentukan oleh komposisi dinding selnya. Oleh karena itu, pengecatan Gram tidak bisa dilakukan pada mikroorganisme yang tidak mempunyai dinding sel sepertiMycoplasma sp. Contoh bakteri yang tergolong bakteri tahan asam, yaitu dari genus Mycobacterium dan beberapa spesies tertentu dari genus Nocardia. Bakteri-bakteri dari kedua genus ini diketahui memiliki sejumlah besar zat lipodial (berlemak) di dalam dinding selnya sehingga menyebabkan dinding sel tersebut relatif tidak permeabel terhadap zat-zat warna yang umum sehingga sel bakteri tersebut tidak terwarnai oleh metode pewarnaan biasa, seperti pewarnaan sederhana atau Gram.
Dalam pewarnaan gram diperlukan reagen yaitu :
a. Zat warna utama (crystal violet)
b. Mordan (larutan Iodin) yaitu senyawa yang digunakan untuk mengintensifkan warna utama.
c. Pencuci/peluntur zat warna (alkohol/aseton) yaitu solven organik yang digunakan uantuk melunturkan zat warna utama.
d. Penutup (safranin) digunakan untuk mewarnai kembali sel-sel yang telah kehilangan cat utama setelah perlakuan dengan alkohol.
d. Penutup (safranin) digunakan untuk mewarnai kembali sel-sel yang telah kehilangan cat utama setelah perlakuan dengan alkohol.
Bakteri Gram negatif adalah bakteri yang tidak mempertahankan zat warna metil ungu pada metode pewarnaan Gram. Bakteri gram positif akan mempertahankan zat warna metil ungu gelap setelah dicuci dengan alkohol, sementara bakteri gram negatif tidak. Pada uji pewarnaan Gram, suatu pewarna penimbal (counter stain) ditambahkan setelah metil ungu, yang membuat semua bakteri gram-negatif menjadi berwarna merah atau merah muda. Pengujian ini berguna untuk mengklasifikasikan kedua tipe bakteri ini berdasarkan perbedaan struktur dinding sel mereka.
Pada proses pewarnaan gram, harus menggunakan object glass yang bersih. Pembersihan ini dilakukan supaya gelas objek bebas lemak dan debu. Pembersihan biasanya menggunakan alkohol. Setelah di cuci kemudian di beri satu tetes aquadest pada permukaan gelas objek. Kultur bakteri murni diambil dan diratakan diatas kaca objek. Pengambilan kultur bakteri tidak diambil terlalu banyak, karena jika terlalu banyak akan sulit diratakan dan apabila kultur bakteri tidak dapat diratakan tipis-tipis maka bakteri akan tertimbun hal ini akan mengakibatkan pemeriksaan bentuknya satu per satu menjadi tidak jelas.
Apabila sudah kering, dilakukan fiksasi dengan cara melewatkan diatas nyala api. Proses fiksasi dilakukan supaya bakteri benar-benar melekat pada kaca objek sehingga olesan bakteri tidak akan terhapus apabila dilakukan pencucian. Yang perlu diperhatikan dalam proses fiksasi adalah bidang yang mengandung bakteri dijaga agar tidak terkena nyala api. Setelah dilakukan fiksasi kemudian ditetesi dengan kristal violet dan dibiarkan. Kemudian dicuci dengan air mengalir dan dibiarkan sampai kering (dengan cara dianginkan). Pencucian dengan air bertujuan untuk mengurangi kelebihan zat warna dari crystal violet. Setelah kelebihan zat warna dicuci dengan air kemudian diberi larutan iodin dan dibiarkan sehingga terbentuk suatu kompleks antara crystal violet dan iodin. Olesan bakteri kemudian dicuci kembali dengan air mengalir. Kemudian dicuci dengan etanol dan dicuci kembali dengan air mengalir.Pewarnaan selanjutnya dengan menggunakan safranin dan diamkan. Kemudian cuci dengan air mengalir dan kering dianginkan, kemudian diamati dibawah mikroskop.
Pemberian kristal violet pada bakteri gram positif akan meninggalkan warna ungu muda. Perbedaan respon terhadap mekanisme pewarnaan gram pada bakteri adalah didasarkan pada struktur dan komposisi dinding sel bakteri. Bakteri gram positif mengandung protein dan gram negatif mengandung lemak dalam persentasi lebih tinggi dan dinding selnya tipis. Pemberian alkohol (etanol) pada praktikum pewarnaan bakteri, menyebabkan terekstraksi lipid sehingga memperbesar permeabilitas dinding sel. Pewarnaan safranin masuk ke dalam sel dan menyebabkan sel menjadi berwarna merah pada bakteri gram negatif sedangkan pada bakteri gram positif dinding selnya terdehidrasi dengan perlakuan alkohol, pori – pori mengkerut, daya rembes dinding sel dan membran menurun sehingga pewarna safranin tidak dapat masuk sehingga sel berwarna ungu.
Perbedaan dasar antara bakteri gram positif dan negatif adalah pada komponen dinding selnya. Kompleks zat iodin terperangkap antara dinding sel dan membran sitoplasma organisme gram positif, sedangkan penyingkiran zat lipida dari dinding sel organisme gram negatif dengan pencucian alkohol memungkinkan hilang dari sel. Bakteri gram positif memiliki membran tunggal yang dilapisi peptidohlikan yang tebal (25-50 nm) sedangkan bakteri negatif lapisan peptidoglikogennya tipis (1-3 nm).
Beberapa perbedaan sifat yang dapat dijumpai antara bakteri Gram positif dan bakteri Gram negatif, yaitu:
Ciri-ciri bakteri gram negatif:
1. Struktur dinding selnya tipis, sekitar 10 – 15 mm, berlapis tiga atau multilayer.
2. Dinding selnya mengandung lemak lebih banyak (11-22%), peptidoglikanterdapat didalam.
3. Lapisan kaku, sebelah dalam dengan jumlah sedikit ± 10% dari berat kering, tidak mengandung asam tekoat.
4. Kurang rentan terhadap senyawa penisilin.
5. Pertumbuhannya tidak begitu dihambat oleh zat warna dasar misalnya kristal violet.
6. Komposisi nutrisi yang dibutuhkan relatif sederhana.
7. Tidak resisten terhadap gangguan fisik.
8. Resistensi terhadap alkali (1% KOH) lebih pekat.
9. Peka terhadap streptomisin.
10. Toksin yang dibentuk Endotoksin.
Ciri-ciri bakteri gram positif:
1. Struktur dinding selnya tebal, sekitar 15-80 nm, berlapis tunggal atau monolayer.
2. Dinding selnya mengandung lipid yang lebih normal (1-4%), peptidoglikan adayang sebagai lapisan
tunggal.
tunggal.
3. Komponen utama merupakan lebih dari 50% beratringan. Mengandung asam tekoat.
4. Bersifat lebih rentan terhadap penisilin.
5. Pertumbuhan dihambat secara nyata oleh zat-zat warna seperti crystal violet.
6. Komposisi nutrisi yang dibutuhkan lebih rumit.
7. Lebih resisten terhadap gangguan fisik.
8. Resistensi terhadap alkali (1% KOH) larut.
9. Tidak peka terhadap streptomisin.
Apabila ada tutur kata yang salah ataupun pembahasan yang kurang detail mohon maaf sebesar-besarnya..

0 comments:
Post a Comment